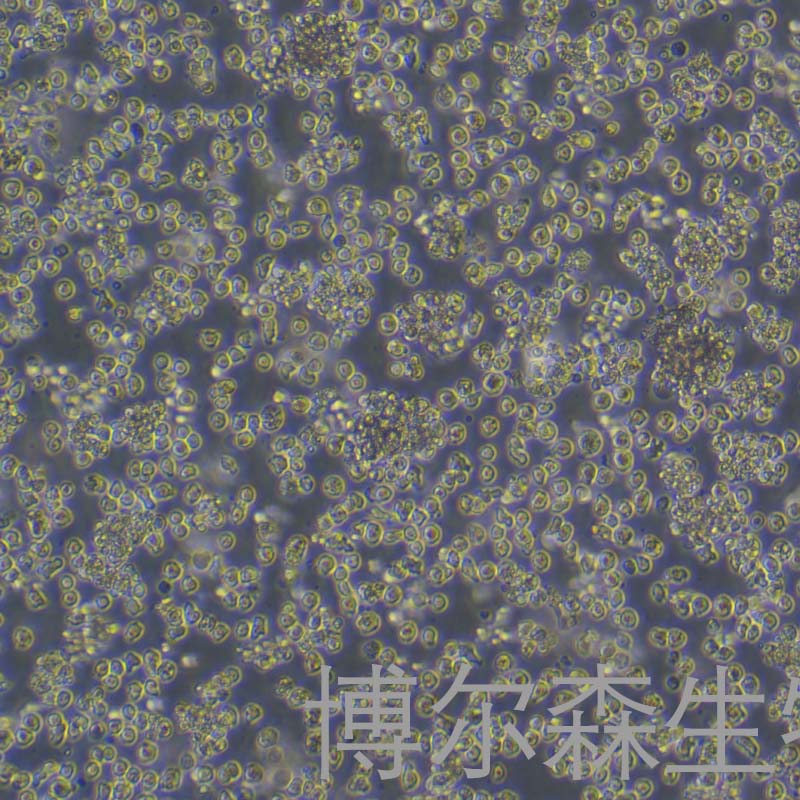
NOMO-1细胞（人白血病细胞）

NOMO-1细胞(人白血病细胞)
NOMO-1
¥3500
1株
起订
上海 更新日期:2026-04-17
产品详情:
- 中文名称:
- NOMO-1细胞(人白血病细胞)
- 英文名称:
- NOMO-1
- 品牌:
- 博尔森/BIOESN
- 产地:
- 上海
- 保存条件:
- 气相:95%空气+5%二氧化碳;温度:37℃
- 纯度规格:
- ≥99%
- 产品类别:
- 细胞系 human细胞系
- 种属:
- 人
- 组织:
- 白血病
- 细胞系:
- 肿瘤细胞
- 细胞形态:
- 圆形
- 生长状态:
- 悬浮生长
- 培养基:
- RPMI-1640+10%FBS+1% 青霉素 - 链霉素混合液
公司简介
上海博尔森生物科技有限公司成立于2020年09月02日,注册地位于上海市松江区石湖荡镇石湖新路95号,经营范围包括一般项目:从事生物科技、医药科技领域内的技术开发、技术咨询、技术服务;仪器仪表、实验室设备及耗材、玻璃制品、电子产品、第一类医疗器械、化工原料及产品(除危险化学品、监控化学品、烟花爆竹、民用爆炸物品、易制毒化学品)销售;货物或技术进出口(国家禁止或涉及行政审批的货物和技术进出口除外)。(除依法须经批准的项目外,凭营业执照依法自主开展经营活动)
上海博尔森生物科技有限公司虽然年轻,但朝气蓬勃,志向远大; 更是一家专注于生命科学与生物技术领域,集产品研发、生产、销售为一体的高科技公司,并立志以竞争力的价格向客户输送高质量的生物试剂。
BIOESN研究领域及主要产品 :
主要研究领域是生命科学,包括分子生物学、细胞生物学、免疫学试剂、重组蛋白,抗体,实验技术服务等多个应用领域。主要产品有:Elisa检测试剂盒、PCR检测试剂盒、抗体、重组蛋白,蛋白定制,细胞系,原代细胞,常用实验试剂,染色液等科研产品。
| 成立日期 | (6年) |
| 注册资本 | 100万 |
| 员工人数 | 10-50人 |
| 年营业额 | ¥ 100万以内 |
| 经营模式 | 试剂,服务 |
| 主营行业 | 生化试剂,抗体,蛋白组学,分子生物学,细胞生物学 |
NOMO-1细胞(人白血病细胞)相关厂家报价
-

- NOMO-1人白血病传代细胞系
- 上海弘顺生物科技有限公司 VIP
- 2026-04-19
- 询价
-

- NOMO-1人白血病复苏细胞(附STR鉴定报告)
- 上海冠导生物工程有限公司 VIP
- 2026-04-19
- 询价
-

- NOMO1人急性髓细胞白血病复苏细胞|送STR报告
- 上海宾穗生物科技有限公司 VIP
- 2026-04-19
- 询价
-

- NOMO-1人急性单核细胞白血病细胞
- 上海雅吉生物科技有限公司 VIP
- 2026-04-18
- ¥1800
-

- NOMO-1人白血病细胞
- 上海博湖生物科技有限公司 VIP
- 2026-04-17
- ¥8800
-

- NOMO-1(人白血病细胞)YB-72032HC
- 上海钰博生物科技有限公司 VIP
- 2026-03-26
- ¥3150
-

- NOMO-1细胞(白血病细胞)LM8C1153
- 上海联迈生物工程有限公司 VIP
- 2026-01-28
- ¥3500
-

- NOMO-1人白血病细胞
- 广州弗尔博生物科技有限公司
- 2026-01-07
- 询价
-

- NOMO1人急性髓细胞白血病细胞库|培养基|带STR图谱
- 上海宾穗生物科技有限公司
- 2025-12-31
- 询价
-

- NOMO-1人白血病细胞
- 厦门逸漠生物科技有限公司
- 2023-11-17
- ¥1800